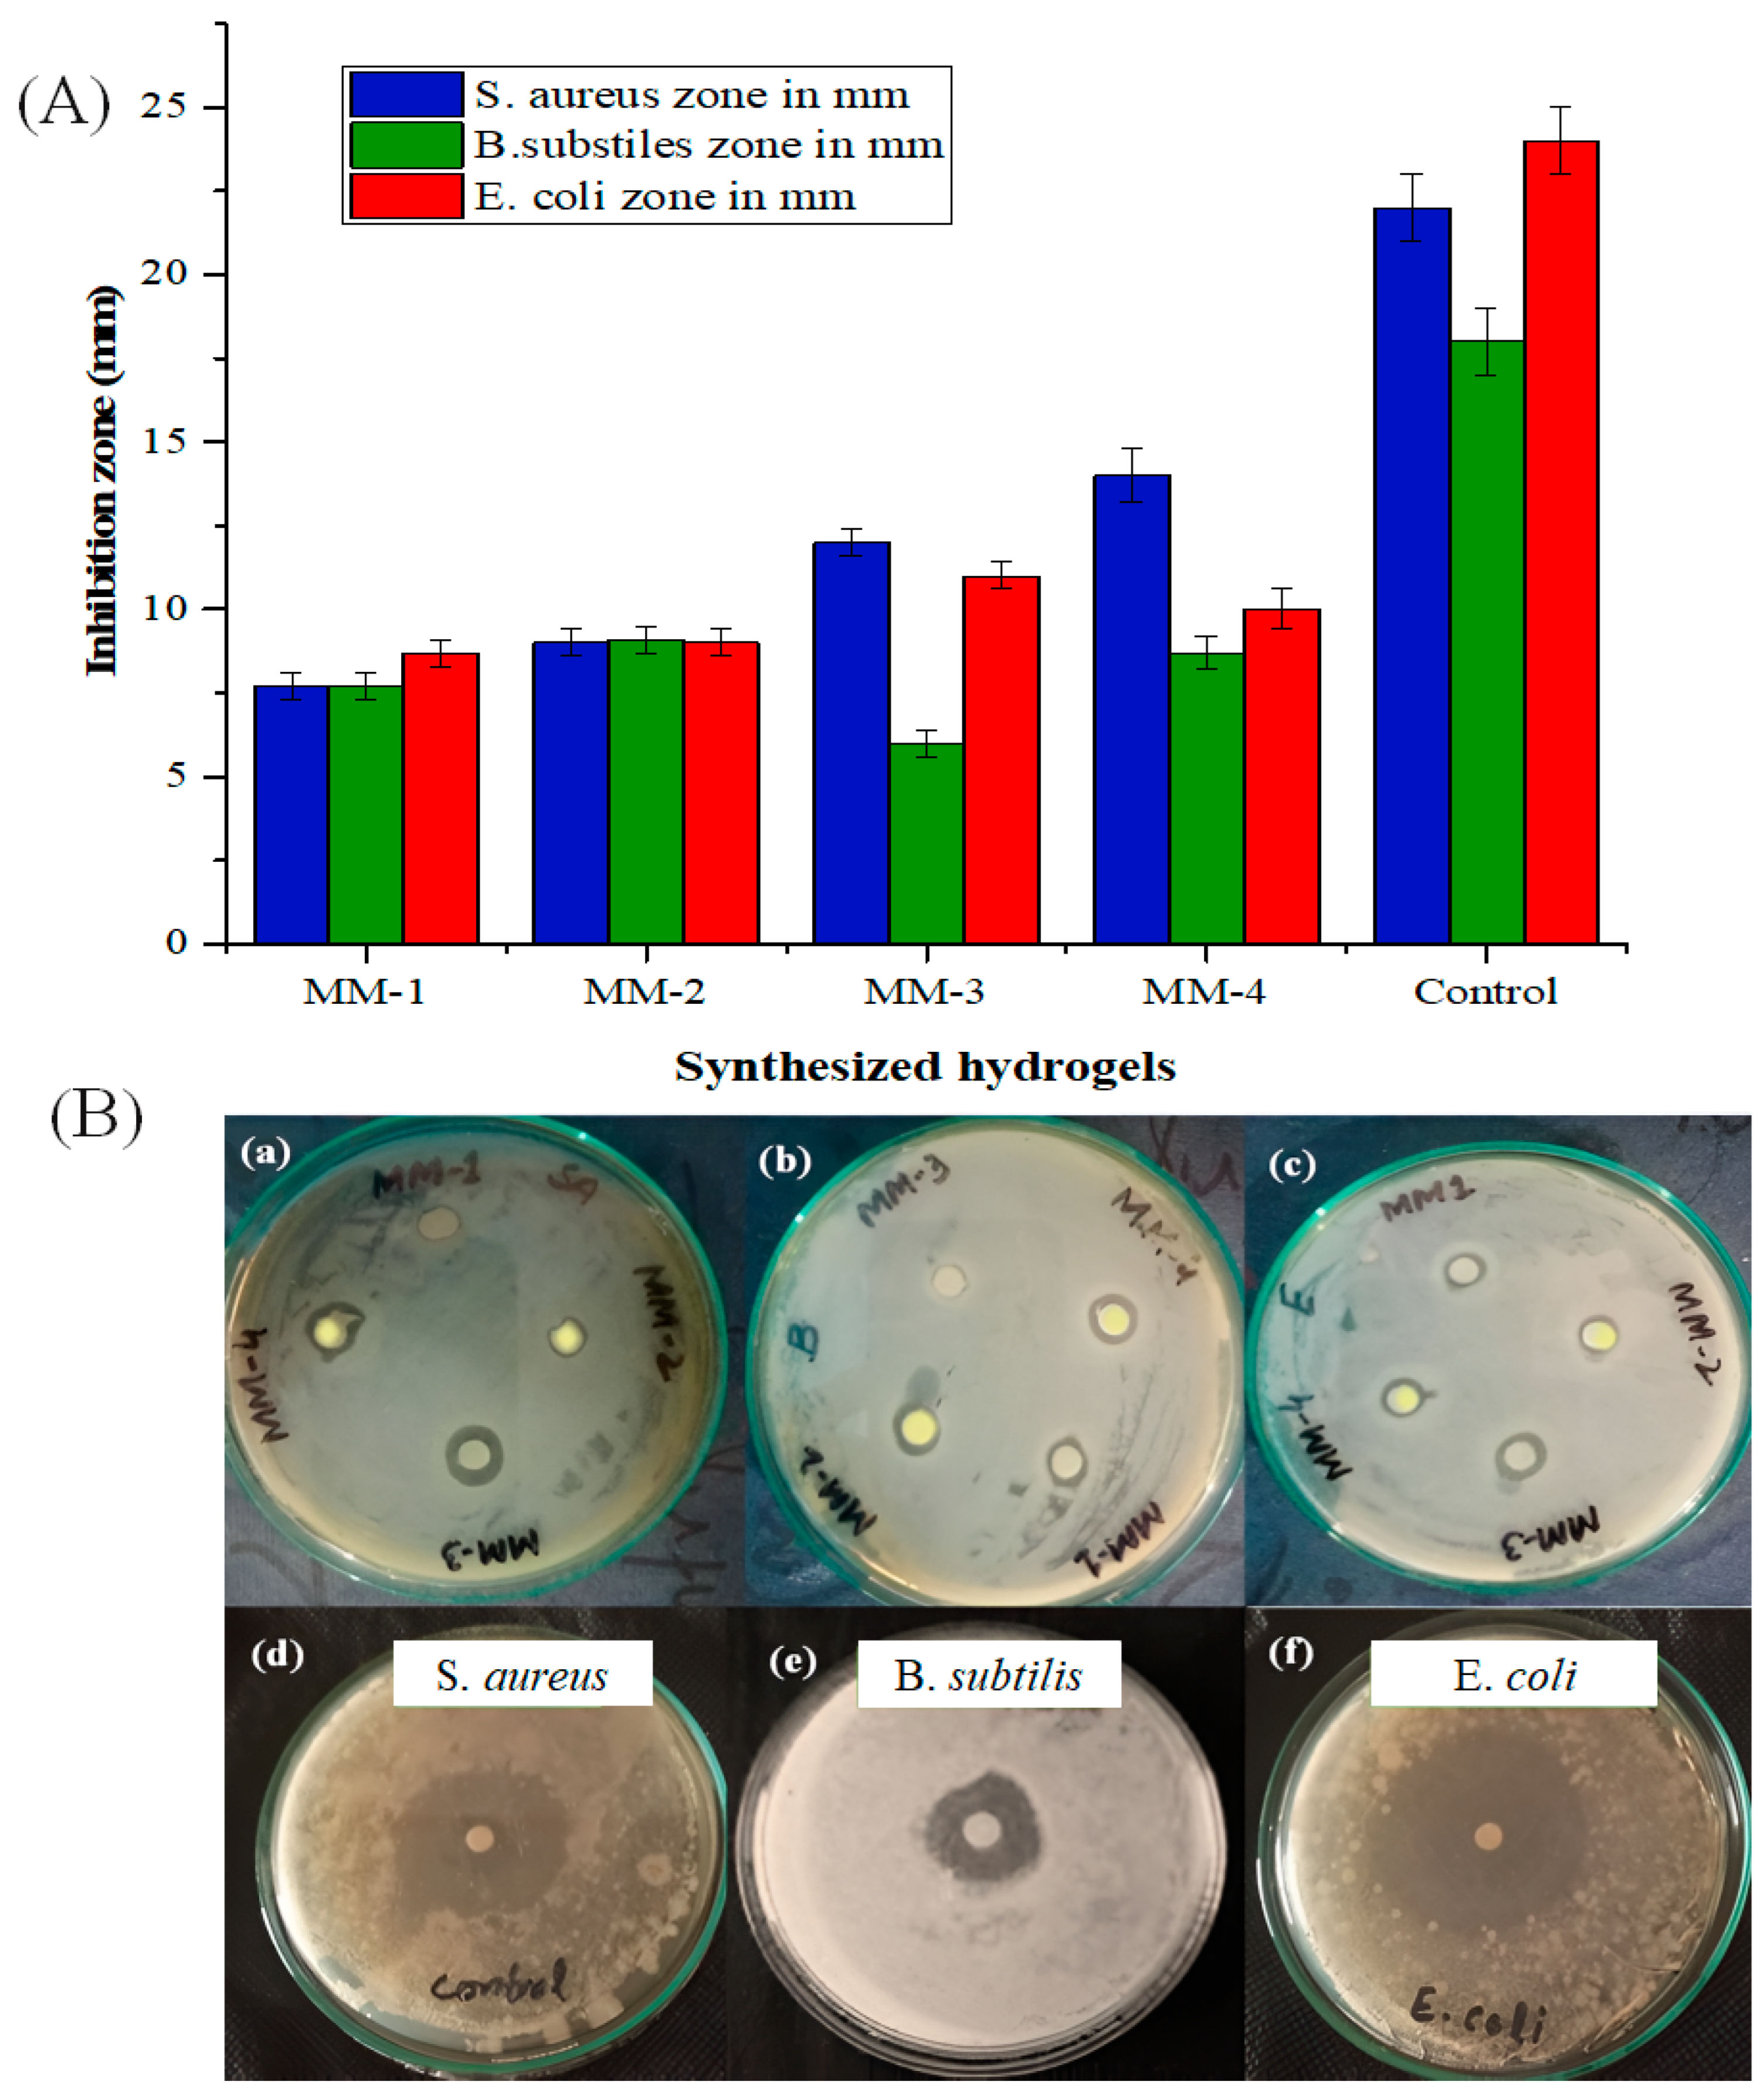
Bioengineering 12 00439 g011

Formulation and Evaluation of Licorice-Extract-Enhanced Chitosan, PVA, and Gelatin-Derived Hydrogels for Wound Dressing
Abstract
1. Introduction
2. Materials, Synthesis, and Characterization
2.1. Chemicals
2.1.1. Preparation of Licorice Extract (LE)
2.1.2. Synthesis of CS/PVA/GEL/LE Hydrogels
2.2. Physical and Structural Characterization of Hydrogels
2.3. Measurement of Total Phenolic and Flavonoid Contents
2.4. Physical and Functional Assessments of the Hydrogels
2.5. Antibacterial Activities of Synthesized Hydrogels
2.6. Anti-Hemolytic/Cytotoxicity Analysis of the Hydrogels
2.7. Biodegradation Studies
2.8. Anti-Oxidant Properties
2.9. Statistical Analysis
3. Results and Discussion
3.1. Structural and Morphological Analysis
3.2. Crystallinity Patterns
3.3. Characterization of Hydrogel Properties for Wound Healing
3.4. Biocompatibility and Antibacterial Properties of Hydrogels
3.5. Biodegradation Performance
3.6. Anti-Oxidant Potential of Hydrogels
4. Conclusions
Supplementary Materials
Author Contributions
Funding
Institutional Review Board Statement
Informed Consent Statement
Data Availability Statement
Conflicts of Interest
References
- Parvinnasab, A.; Shahroudi, S.; Salahinejad, E.; Taghvaei, A.H.; Fard, S.A.S.; Sharifi, E. Antibacterial nanofibrous wound dressing mats made from blended chitosan-copper complexes and polyvinyl alcohol (PVA) using electrospinning. Carbohydr. Polym. Technol. Appl. 2024, 8, 100564. [Google Scholar] [CrossRef]
- Suneetha, M.; Hemalatha, D.; Kim, H.; Rao, K.K.; Han, S.S. Vanillin/fungal-derived carboxy methyl chitosan/polyvinyl alcohol hydrogels prepared by freeze-thawing for wound dressing applications. Int. J. Biol. Macromol. 2024, 266, 130910. [Google Scholar] [CrossRef] [PubMed]
- Naveed, A.; Naqvi, S.S.; Khan, T.M.; Razzak, I. PCA: Progressive class-wise attention for skin lesions diagnosis. Eng. Appl. Artif. Intell. 2024, 127, 107417. [Google Scholar] [CrossRef]
- Wichaiyo, S.; Tachiki, K.; Igaue, T. Pyroxylin-based liquid bandage forms a mechanically active protective film to facilitate skin wound healing in mice. Biomed. Pharmacother. 2024, 179, 117307. [Google Scholar] [CrossRef]
- Zhang, W.; Liu, L.; Cheng, H.; Zhu, J.; Li, X.; Ye, S.; Li, X. Hydrogel-based dressings designed to facilitate wound healing. Mater. Adv. 2024, 5, 1364–1394. [Google Scholar] [CrossRef]
- Qiao, L.; Liang, Y.; Chen, J.; Huang, Y.; Alsareii, S.A.; Alamri, A.M.; Harraz, F.A.; Guo, B. Antibacterial conductive self-healing hydrogel wound dressing with dual dynamic bonds promotes infected wound healing. Bioact. Mater. 2023, 30, 129–141. [Google Scholar] [CrossRef]
- Akram, M.W.; Hoque, M.M.; Miah, M.S.; Shahid, M.A.; Hossain, M.F.; Mahmud, S.H. Fabrication and characterization of antimicrobial wound dressing nanofibrous materials by PVA-betel leaf extract. Heliyon 2023, 9, e17961. [Google Scholar] [CrossRef]
- Fatima, M.; Iqbal, Y.; Ahmad, M.M.; Chatha, S.A.S.; Khan, I.; Hussain, A.I. Fabrication and evaluation of CMC-Ag and CMC-Zn-based composite films as biobased wound dressings. Carbohydr. Polym. Technol. Appl. 2024, 7, 100476. [Google Scholar] [CrossRef]
- Wichaiyo, S.; Svasti, S.; Maiuthed, A.; Rukthong, P.; Goli, A.S.; Morales, N.P. Dasatinib Ointment Promotes Healing of Murine Excisional Skin Wound. ACS Pharmacol. Transl. Sci. 2023, 6, 1015–1027. [Google Scholar] [CrossRef]
- Wei, C.; Xing, S.; Li, Y.; Koosha, M.; Wang, S.; Chen, H.; Zhai, Y.; Wang, L.; Yang, X.; Fakhrullin, R. Gelatin/carboxymethyl chitosan/aloe juice hydrogels with skin-like endurance and quick recovery: Preparation, characterization, and properties. Int. J. Biol. Macromol. 2024, 261, 129720. [Google Scholar] [CrossRef]
- Amirabad, A.A.; Johari, M.; Parichehr, R.; Aghdam, R.M.; Dehghanian, C.; Allahkaram, S.R. Improving corrosion, antibacterial and biocompatibility properties of MAO-coated AZ31 magnesium alloy by Cu (II)-chitosan/PVA nanofibers post-treatment. Ceram. Int. 2023, 49, 17371–17382. [Google Scholar] [CrossRef]
- Wang, T.; Zhu, X.-K.; Xue, X.-T.; Wu, D.-Y. Hydrogel sheets of chitosan, honey and gelatin as burn wound dressings. Carbohydr. Polym. 2012, 88, 75–83. [Google Scholar] [CrossRef]
- Kumar, N.; Bose, P.; Kumar, S.; Daksh, S.; Verma, Y.K.; Roy, B.G.; Som, S.; Singh, J.D.; Datta, A. Nanoapatite-Loaded κ-Carrageenan/Poly (vinyl alcohol)-Based Injectable Cryogel for Hemostasis and Wound Healing. Biomacromolecules 2024, 25, 1228–1245. [Google Scholar] [CrossRef] [PubMed]
- Li, S.; Dou, W.; Ji, W.; Li, X.; Chen, N.; Ji, Y.; Zeng, X.; Sun, P.; Li, Y.; Liu, C.; et al. Tissue-adhesive, stretchable and compressible physical double-crosslinked microgel-integrated hydrogels for dynamic wound care. Acta Biomater. 2024, 184, 186–200. [Google Scholar] [CrossRef]
- Reisi-Vanani, V.; Hosseini, S.; Soleiman-Dehkordi, E.; Boroujeni, S.N.; Farzan, M.; Ebani, V.V.; Gholipourmalekabadi, M.; Lozano, K.; Lorigooini, Z. Engineering of a core-shell polyvinyl alcohol/gelatin fibrous scaffold for dual delivery of Thymus daenensis essential oil and Glycyrrhiza glabra L. extract as an antibacterial and functional wound dressing. J. Drug Deliv. Sci. Technol. 2023, 81, 104282. [Google Scholar] [CrossRef]
- Adamu, B.F.; Gao, J.; Xiangnan, Y.; Tan, S.; Zhao, H.; Jhatial, A.K. Rhamnus prinoides leaf extract loaded polycaprolactone-cellulose acetate nanofibrous scaffold as potential wound dressing: An in vitro study. Int. J. Biol. Macromol. 2024, 279, 134934. [Google Scholar] [CrossRef]
- Gounden, V.; Singh, M. Hydrogels and Wound Healing: Current and Future Prospects. Gels 2024, 10, 43. [Google Scholar] [CrossRef]
- Demirhan, I.; Korkmaz, A.; Oner, E.; Gumuscu, N.; Erbil, Y.; Babaarslan, O.; Kurutas, E.B. Synthesis, characterization, and antibacterial effect of St. John’s wort oil loaded chitosan hydrogel. Int. J. Biol. Macromol. 2024, 260, 129444. [Google Scholar] [CrossRef]
- Mobarakeh, A.I.; Ramsheh, A.S.; Khanshan, A.; Aghaei, S.; Mirbagheri, M.S.; Esmaeili, J. Fabrication and evaluation of a bi-layered electrospun PCL/PVA patch for wound healing: Release of vitamins and silver nanoparticle. Heliyon 2024, 10, e33178. [Google Scholar] [CrossRef]
- Nemati, M.M.; Heidari, R.; Keshavarzi, A.; Ahmadi, A.; Abedi, M.; Ranjbar, S.; Ghasemi, Y. In Vitro and In Vivo Evaluation of Electrospun PVA Nanofiber Containing ZnO/Curcumin for Wound Healing Application. Appl. Biochem. Biotechnol. 2025, 197, 194–215. [Google Scholar] [CrossRef]
- Kancha, M.M.; Mehrabi, M.; Aghaie, F.; Bitaraf, F.S.; Dehghani, F.; Bernkop-Schnürch, A. Preparation and characterization of PVA/chitosan nanofibers loaded with Dragon’s blood or poly helixan as wound dressings. Int. J. Biol. Macromol. 2024, 272, 132844. [Google Scholar]
- Singh, B.; Singh, J.; Sharma, V.; Kumari, A.; Sharma, D. Exploring bioactive aloe-vera and sterculia gum to develop hydrogel wound dressings by graft-copolymerization. Food Hydrocoll. Health 2023, 4, 100168. [Google Scholar] [CrossRef]
- Li, L.; Chen, D.; Chen, J.; Yang, C.; Zeng, Y.; Jin, T.; Zhang, Y.; Sun, X.; Mao, H.; Mu, Z.; et al. Gelatin and catechol-modified quaternary chitosan cotton dressings with rapid hemostasis and high-efficiency antimicrobial capacity to manage severe bleeding wounds. Mater. Des. 2023, 229, 111927. [Google Scholar] [CrossRef]
- Xie, X.; Li, D.; Chen, Y.; Shen, Y.; Yu, F.; Wang, W.; Yuan, Z.; Morsi, Y.; Wu, J.; Mo, X. Conjugate electrospun 3D gelatin nanofiber sponge for rapid hemostasis. Adv. Healthc. Mater. 2021, 10, 2100918. [Google Scholar] [CrossRef]
- Gong, M.; Shi, H.; Hu, Z.; Wang, F.; Dong, M.; Lei, R.; Zeng, Z.; Wang, Y.; Chen, J. Aerogel-hydrogel biphase gels based on physically crosslinked β-lactoglobulin fibrils/polyvinyl alcohol for skin wound dressings: In vitro and in vivo characterization. Chem. Eng. J. 2023, 473, 145394. [Google Scholar] [CrossRef]
- Norris, K.; Kocot, M.; Tryba, A.M.; Chai, F.; Talari, A.; Ashton, L.; Parakhonskiy, B.V.; Samal, S.K.; Blanchemain, N.; Pamuła, E.; et al. Marine-inspired enzymatic mineralization of dairy-derived whey protein isolate (WPI) hydrogels for bone tissue regeneration. Mar. Drugs 2020, 18, 294. [Google Scholar] [CrossRef]
- Nyström, G.; Roder, L.; Fernández-Ronco, M.P.; Mezzenga, R. Amyloid templated organic–inorganic hybrid aerogels. Adv. Funct. Mater. 2018, 28, 1703609. [Google Scholar] [CrossRef]
- Zehra, A.; Bokhari, N.; Nosheen, S.; Bashir, M.; Khan, A.; Khan, F.A.; Muhammad, N.; Sharif, F. Electrospun bilayer membranes carrying bearberry/licorice extract to ameliorate wound healing. J. Polym. Environ. 2024, 32, 735–748. [Google Scholar] [CrossRef]
- Sallustio, V.; Rossi, M.; Mandrone, M.; Rossi, F.; Chiocchio, I.; Cerchiara, T.; Longo, E.; Fratini, M.; D’Amico, L.; Tromba, G.; et al. A promising eco-sustainable wound dressing based on cellulose extracted from Spartium junceum L. and impregnated with Glycyrrhiza glabra L extract: Design, production and biological properties. Int. J. Biol. Macromol. 2024, 272, 132883. [Google Scholar] [CrossRef]
- Patole, V.; Ingavle, G.; Behere, I.; Nehere, T.; Kolhe, P.; Baheti, R.; Swami, D. Emerging trends in polysaccharide based cryogel scaffold for skin tissue engineering. Int. J. Polym. Mater. Polym. Biomater. 2024, 1–19. [Google Scholar] [CrossRef]
- Rossello, S.; Mandrone, M.; Cerchiara, T.; Chiocchio, I.; Rossi, M.; Chinnici, F.; Sallustio, V.; Aponte, M.; Blaiotta, G.; Luppi, B.; et al. A New Wound-Healing Tool Based on Glycyrrhiza glabra Extract-Loaded Ufasomes on Spanish Broom Dressings. Molecules 2024, 29, 3811. [Google Scholar] [CrossRef] [PubMed]
- Zhang, Y.; Lu, J.; Chang, T.; Tang, X.; Wang, Q.; Pan, D.; Wang, J.; Nan, H.; Zhang, W.; Liu, L.; et al. A bibliometric review of Glycyrrhizae Radix et Rhizoma (licorice) research: Insights and future directions. J. Ethnopharmacol. 2023, 321, 117409. [Google Scholar] [CrossRef] [PubMed]
- AlDehlawi, H.; Jazzar, A. The Power of Licorice (Radix glycyrrhizae) to Improve Oral Health: A Comprehensive Review of Its Pharmacological Properties and Clinical Implications. Healthcare 2023, 11, 2887. [Google Scholar] [CrossRef]
- Shahid, F.; Noreen; Ali, R.; Badshah, S.L.; Jamal, S.B.; Ullah, R.; Bari, A.; Mahmood, H.M.; Sohaib, M.; Ansari, S.A. Identification of potential HCV inhibitors based on the interaction of epigallocatechin-3-gallate with viral envelope proteins. Molecules 2021, 26, 1257. [Google Scholar] [CrossRef] [PubMed]
- Angioi, R.; Morrin, A.; White, B. The rediscovery of honey for skin repair: Recent advances in mechanisms for honey-mediated wound healing and scaffolded application techniques. Appl. Sci. 2021, 11, 5192. [Google Scholar] [CrossRef]
- Mondal, K.; Bhattacharjee, S.K.; Mudenur, C.; Ghosh, T.; Goud, V.V.; Katiyar, V. Development of antioxidant-rich edible active films and coatings incorporated with de-oiled ethanolic green algae extract: A candidate for prolonging the shelf life of fresh produce. RSC Adv. 2022, 12, 13295–13313. [Google Scholar] [CrossRef]
- Maria, A.A.; Salem, R.H.; Salama, M.A.; Khalil, A.M.M. Antioxidant-Rich Biodegradable Films: Incorporating Date Phenolic Extracts into Polyvinyl Alcohol Biofilms for Strawberry Preservation. J. Food Dairy Sci. 2024, 15, 203–217. [Google Scholar] [CrossRef]
- Khan, A.; Andleeb, A.; Azam, M.; Tehseen, S.; Mehmood, A.; Yar, M. Aloe vera and ofloxacin incorporated chitosan hydrogels show antibacterial activity, stimulate angiogenesis and accelerate wound healing in full thickness rat model. J. Biomed. Mater. Res. Part B Appl. Biomater. 2023, 111, 331–342. [Google Scholar] [CrossRef]
- Attard, E. A rapid microtitre plate Folin-Ciocalteu method for the assessment of polyphenols. Open Life Sci. 2013, 8, 48–53. [Google Scholar] [CrossRef]
- Lister, E.; Wilson, P. Measurement of Total Phenolics and ABTS Assay for Antioxidant Activity (Personal Communication); Crop Research Institute: Lincoln, New Zealand, 2001; Volume 7, pp. 235–239. [Google Scholar]
- Orujei, Y.; Shabani, L.; Sharifi-Tehrani, M. Induction of glycyrrhizin and total phenolic compound production in licorice by using arbuscular mycorrhizal fungi. Russ. J. Plant Physiol. 2013, 60, 855–860. [Google Scholar] [CrossRef]
- Shafique, M.; Sohail, M.; Minhas, M.U.; Khaliq, T.; Kousar, M.; Khan, S.; Hussain, Z.; Mahmood, A.; Abbasi, M.; Aziz, H.C.; et al. Bio-functional hydrogel membranes loaded with chitosan nanoparticles for accelerated wound healing. Int. J. Biol. Macromol. 2021, 170, 207–221. [Google Scholar] [CrossRef] [PubMed]
- Martínez-Ibarra, D.M.; Sánchez-Machado, D.I.; López-Cervantes, J.; Campas-Baypoli, O.N.; Sanches-Silva, A.; Madera-Santana, T.J. Hydrogel wound dressings based on chitosan and xyloglucan: Development and characterization. J. Appl. Polym. Sci. 2019, 136, 47342. [Google Scholar] [CrossRef]
- Zheng, A.; Xue, Y.; Wei, D.; Li, S.; Xiao, H.; Guan, Y. Synthesis and characterization of antimicrobial polyvinyl pyrrolidone hydrogel as wound dressing. Soft Mater. 2014, 12, 179–187. [Google Scholar] [CrossRef]
- Li, M.; Dong, Y.; Wang, M.; Lu, X.; Li, X.; Yu, J.; Ding, B. Hydrogel/nanofibrous membrane composites with enhanced water retention, stretchability and self-healing capability for wound healing. Compos. Part B Eng. 2023, 257, 110672. [Google Scholar] [CrossRef]
- Bauer, H.; Paronetto, F.; Burns, W.A.; Einheber, A. The enhancing effect of the microbial flora on macrophage function and the immune response a study in germfree mice. J. Exp. Med. 1966, 123, 1013–1024. [Google Scholar] [CrossRef]
- Chhatri, A.; Bajpai, J.; Bajpai, A.; Sandhu, S.; Jain, N.; Biswas, J. Cryogenic fabrication of savlon loaded macroporous blends of alginate and polyvinyl alcohol (PVA). Swelling, deswelling and antibacterial behaviors. Carbohydr. Polym. 2011, 83, 876–882. [Google Scholar] [CrossRef]
- Rubab, K.; Abbasi, M.A.; Rehman, A.; Siddiqui, S.Z.; Shah, S.A.A.; Ashraf, M.; Ain, Q.; Ahmad, I.; Lodhi, M.A.; Ghufran, M.; et al. Synthesis, pharmacological screening and computational analysis of some 2-(1H-Indol-3-yl)-N′-[(un) substituted phenylmethylidene] acetohydrazides and 2-(1H-Indol-3-yl)-N′-[(un) substituted benzoyl/2-thienylcarbonyl] acetohydrazides. Pak. J. Pharm. Sci. 2017, 30, 1263–1275. [Google Scholar]
- Shahzadi, T.; Zaib, M.; Riaz, T.; Shehzadi, S.; Abbasi, M.A.; Shahid, M. Synthesis of eco-friendly cobalt nanoparticles using Celosia argentea plant extract and their efficacy studies as antioxidant, antibacterial, hemolytic and catalytical agent. Arab. J. Sci. Eng. 2019, 44, 6435–6444. [Google Scholar] [CrossRef]
- Rusanu, A.; Tamaş, A.I.; Vulpe, R.; Rusu, A.; Butnaru, M.; Vereştiuc, L. Biocompatible and biodegradable hydrogels based on chitosan and gelatin with potential applications as wound dressings. J. Nanosci. Nanotechnol. 2017, 17, 4584–4591. [Google Scholar] [CrossRef]
- Kang, B.; Vales, T.P.; Cho, B.-K.; Kim, J.-K.; Kim, H.-J. Development of gallic acid-modified hydrogels using interpenetrating chitosan network and evaluation of their antioxidant activity. Molecules 2017, 22, 1976. [Google Scholar] [CrossRef]
- Nugroho, F.; Nizardo, N.; Saepudin, E. Synthesis of citric acid crosslinked PVA/tapioca starch bioplastic reinforced with grafted cellulose. AIP Conf. Proc. 2020, 2242, 040040. [Google Scholar]
- Upadhyaya, L.; Singh, J.; Agarwal, V.; Tewari, R.P. The implications of recent advances in carboxymethyl chitosan based targeted drug delivery and tissue engineering applications. J. Control Release 2014, 186, 54–87. [Google Scholar] [CrossRef] [PubMed]
- Ilčin, M.; Holá, O.; Bakajová, B.; Kučerík, J. FT-IR study of gamma-radiation induced degradation of polyvinyl alcohol (PVA) and PVA/humic acids blends. J. Radioanal. Nucl. Chem. 2010, 283, 9–13. [Google Scholar] [CrossRef]
- Peng, N.; Widjojo, N.; Sukitpaneenit, P.; Teoh, M.M.; Lipscomb, G.G.; Chung, T.-S.; Lai, J.-Y. Evolution of polymeric hollow fibers as sustainable technologies: Past, present, and future. Prog. Polym. Sci. 2012, 37, 1401–1424. [Google Scholar] [CrossRef]
- Yar, M.; Shahzad, S.; Siddiqi, S.A.; Mahmood, N.; Rauf, A.; Anwar, M.S.; Chaudhry, A.A.; Rehman, I.U. Triethyl orthoformate mediated a novel crosslinking method for the preparation of hydrogels for tissue engineering applications: Characterization and in vitro cytocompatibility analysis. Mater. Sci. Eng. C 2015, 56, 154–164. [Google Scholar] [CrossRef]
- Amin, M.A.; Abdel-Raheem, I.T. Accelerated wound healing and anti-inflammatory effects of physically cross linked polyvinyl alcohol–chitosan hydrogel containing honey bee venom in diabetic rats. Arch. Pharmacal Res. 2014, 37, 1016–1031. [Google Scholar] [CrossRef]
- Zhou, T.; Chen, S.; Ding, X.; Hu, Z.; Cen, L.; Zhang, X. Fabrication and characterization of collagen/PVA dual-layer membranes for periodontal bone regeneration. Front. Bioeng. Biotechnol. 2021, 9, 630977. [Google Scholar] [CrossRef]
- Kumar, A.; Behl, T.; Chadha, S. Synthesis of physically crosslinked PVA/Chitosan loaded silver nanoparticles hydrogels with tunable mechanical properties and antibacterial effects. Int. J. Biol. Macromol. 2020, 149, 1262–1274. [Google Scholar] [CrossRef]
- Debelle, A.; Declémy, A.; Vincent, L.; Garrido, F.; Thomé, L. XRD contribution to the study of Cs-implanted cubic zirconia. J. Nucl. Mater. 2010, 396, 240–244. [Google Scholar] [CrossRef]
- Rinaudo, M. Chitin and chitosan: Properties and applications. Prog. Polym. Sci. 2006, 31, 603–632. [Google Scholar] [CrossRef]
- Ingle, P.U.; Shende, S.S.; Shingote, P.R.; Mishra, S.S.; Sarda, V.; Wasule, D.L.; Rajput, V.D.; Minkina, T.; Rai, M.; Sushkova, S.; et al. Chitosan nanoparticles (ChNPs): A versatile growth promoter in modern agricultural production. Heliyon 2022, 8, e11893. [Google Scholar] [CrossRef] [PubMed]
- Kokabi, M.; Sirousazar, M.; Hassan, Z.M. PVA–clay nanocomposite hydrogels for wound dressing. Eur. Polym. J. 2007, 43, 773–781. [Google Scholar] [CrossRef]
- Al-Hmadi, H.B.; Majdoub, S.; El Mokni, R.; Angeloni, S.; Mustafa, A.M.; Caprioli, G.; Zengin, G.; Maggi, F.; Hammami, S. Metabolite profiling, enzyme inhibitory activity and antioxidant potential of different extracts from Glycyrrhiza foetida Desf.(Fabaceae, Galegeae, Glycyrrhizinae). Fitoterapia 2024, 173, 105792. [Google Scholar] [CrossRef] [PubMed]
- Quintana, S.E.; Cueva, C.; Villanueva-Bermejo, D.; Moreno-Arribas, M.V.; Fornari, T.; García-Risco, M.R. Antioxidant and antimicrobial assessment of licorice supercritical extracts. Ind. Crops Prod. 2019, 139, 111496. [Google Scholar] [CrossRef]
- Vlaisavljević, S.; Šibul, F.; Sinka, I.; Zupko, I.; Ocsovszki, I.; Jovanović-Šanta, S. Chemical composition, antioxidant and anticancer activity of licorice from Fruska Gora locality. Ind. Crops Prod. 2018, 112, 217–224. [Google Scholar] [CrossRef]
- Di Mambro, V.M.; Fonseca, M.J. Assays of physical stability and antioxidant activity of a topical formulation added with different plant extracts. J. Pharm. Biomed. Anal. 2005, 37, 287–295. [Google Scholar] [CrossRef]
- Zhang, L.; Liu, M.; Zhang, Y.; Pei, R. Recent progress of highly adhesive hydrogels as wound dressings. Biomacromolecules 2020, 21, 3966–3983. [Google Scholar] [CrossRef]
- Zhang, C.-H.; Yang, F.-L.; Wang, W.-J.; Chen, B. Preparation and characterization of hydrophilic modification of polypropylene non-woven fabric by dip-coating PVA (polyvinyl alcohol). Sep. Purif. Technol. 2008, 61, 276–286. [Google Scholar] [CrossRef]
- Jin, L.; Yoon, S.-J.; Lee, D.H.; Pyun, Y.C.; Kim, W.Y.; Lee, J.H.; Khang, G.; Chun, H.J.; Yang, D.H. Preparation of foam dressings based on gelatin, hyaluronic acid, and carboxymethyl chitosan containing fibroblast growth factor-7 for dermal regeneration. Polymers 2021, 13, 3279. [Google Scholar] [CrossRef]
- Jiang, Y.; Hou, Y.; Fang, J.; Liu, W.; Zhao, Y.; Huang, T.; Cui, J.; Yang, Y.; Zhou, Z. Preparation and characterization of PVA/SA/HA composite hydrogels for wound dressing. Int. J. Polym. Anal. Charact. 2019, 24, 132–141. [Google Scholar] [CrossRef]
- Hassan, M.A.; Tamer, T.M.; Valachová, K.; Omer, A.M.; El-Shafeey, M.; Eldin, M.S.M.; Šoltés, L. Antioxidant and antibacterial polyelectrolyte wound dressing based on chitosan/hyaluronan/phosphatidylcholine dihydroquercetin. Int. J. Biol. Macromol. 2021, 166, 18–31. [Google Scholar] [CrossRef]
- Ma, L.; Yu, W.; Ma, X. Preparation and characterization of novel sodium alginate/chitosan two ply composite membranes. J. Appl. Polym. Sci. 2007, 106, 394–399. [Google Scholar] [CrossRef]
- Soubhagya, A.; Moorthi, A.; Prabaharan, M. Preparation and characterization of chitosan/pectin/ZnO porous films for wound healing. Int. J. Biol. Macromol. 2020, 157, 135–145. [Google Scholar] [CrossRef]
- Liu, W.; Li, X.; Wang, S.; Fang, F.; Wang, X.; Hou, Q. Nanocomposites derived from licorice residues cellulose nanofibril and chitosan nanofibril: Effects of chitosan nanofibril dosage on resultant properties. Int. J. Biol. Macromol. 2020, 165, 2404–2411. [Google Scholar] [CrossRef] [PubMed]
- Hudzicki, J. Kirby-Bauer disk diffusion susceptibility test protocol. Am. Soc. Microbiol. 2009, 15, 1–23. [Google Scholar]
- Shamloo, A.; Aghababaie, Z.; Afjoul, H.; Jami, M.; Bidgoli, M.R.; Vossoughi, M.; Ramazani, A.; Kamyabhesari, K. Fabrication and evaluation of chitosan/gelatin/PVA hydrogel incorporating honey for wound healing applications: An in vitro, in vivo study. Int. J. Pharm. 2021, 592, 120068. [Google Scholar] [CrossRef]
- Hajji, S.; Khedir, S.B.; Hamza-Mnif, I.; Hamdi, M.; Jedidi, I.; Kallel, R.; Boufi, S.; Nasri, M. Biomedical potential of chitosan-silver nanoparticles with special reference to antioxidant, antibacterial, hemolytic and in vivo cutaneous wound healing effects. Biochim. Biophys. Acta (BBA)-Gen. Subj. 2019, 1863, 241–254. [Google Scholar] [CrossRef]
- Matica, M.A.; Aachmann, F.L.; Tøndervik, A.; Sletta, H.; Ostafe, V. Chitosan as a wound dressing starting material: Antimicrobial properties and mode of action. Int. J. Mol. Sci. 2019, 20, 5889. [Google Scholar] [CrossRef]
- Ashraf, H.; Salim, S.A.; El-Moslamy, S.H.; Loutfy, S.A.; Kamoun, E.A. An Injectable In Situ Forming Collagen/Alginate/CaSO4 Composite Hydrogel for Tissue Engineering Applications: Optimization, Characterization and In Vitro Assessments. Arab. J. Sci. Eng. 2024, 49, 9577–9591. [Google Scholar] [CrossRef]
- Stan, D.; Codrici, E.; Enciu, A.M.; Olewnik-Kruszkowska, E.; Gavril, G.; Ruta, L.L.; Moldovan, C.; Brincoveanu, O.; Bocancia-Mateescu, L.A.; Mirica, A.C.; et al. Exploring the Impact of Alginate—PVA Ratio and the Addition of Bioactive Substances on the Performance of Hybrid Hydrogel Membranes as Potential Wound Dressings. Gels 2023, 9, 476. [Google Scholar] [CrossRef]
- Francesko, A.; Petkova, P.; Tzanov, T. Hydrogel dressings for advanced wound management. Curr. Med. Chem. 2018, 25, 5782–5797. [Google Scholar] [CrossRef] [PubMed]
- Zhou, C.; Sheng, C.; Chen, J.; Liang, Y.; Liu, Q.; Li, P.; Huang, X.; Liu, B. Gradual hydrogel degradation for programable repairing full-thickness skin defect wound. Chem. Eng. J. 2022, 450, 138200. [Google Scholar] [CrossRef]
- Ibrahim, R.M.; Kamoun, E.A.; Badawi, N.M.; El-Moslamy, S.H.; Kh., M.; Salim, S.A. Cutting-edge biomaterials for advanced biomedical uses: Self-gelation of l-arginine-loaded chitosan/PVA/vanillin hydrogel for accelerating topical wound healing and skin regeneration. RSC Adv. 2024, 14, 31126–31142. [Google Scholar] [CrossRef] [PubMed]
- Kaya, H.; Bulut, O.; Kamali, A.R.; Ege, D. L-Arginine modified multi-walled carbon nanotube/sulfonated poly (ether ether ketone) nanocomposite films for biomedical applications. Appl. Surf. Sci. 2018, 444, 168–176. [Google Scholar] [CrossRef]
- Xu, Z.; Han, S.; Gu, Z.; Wu, J. Advances and impact of antioxidant hydrogel in chronic wound healing. Adv. Healthc. Mater. 2020, 9, 1901502. [Google Scholar] [CrossRef]
- Tsala, D.E.; Nnanga, N.; Ndzana, M.T.B.; Mballa, B.T.; Dimo, T. Evaluation of the antioxidant activity and the healing action of the ethanol extract of Calotropis procera bark against surgical wounds. J. Intercult. Ethnopharmacol. 2015, 4, 64. [Google Scholar] [CrossRef]

| Materials Used | Bioactive Agent | Key Findings | Advantages | Disadvantages | References |
|---|---|---|---|---|---|
| Chitosan, Gelatin | Aloe Vera Extract | Effective wound healing and moderate antibacterial properties | Biocompatibility, promotes tissue regeneration | Relatively slow degradation rate | [10] |
| PVA, Gelatin | Honey | Excellent antibacterial activity | High antibacterial potential due to honey’s properties | Sticky texture and slow degradation rate | [35] |
| Alginate, Chitosan | Green Tea Extract | Enhanced antioxidant and antibacterial properties | Antioxidant-rich, biocompatible | Limited mechanical strength | [36] |
| Chitosan, PVA | Curcumin | Strong antibacterial activity, improved healing | Potent antibacterial agent, easy to incorporate | Poor water retention and stability | [37] |
| Chitosan, PVA, Gelatin | Licorice Extract | Good antibacterial and swelling properties | Natural bioactive agent with antibacterial and wound healing properties | - | This study |
| Sr. No. | Sample Code | CS (mL) | PVA (mL) | GEL (mL) | LE (mL) |
|---|---|---|---|---|---|
| 1 | MM-1 | 20 | 20 | 3 | - |
| 2 | MM-2 | 20 | 20 | 3 | 4 |
| 3 | MM-3 | 28 | 12 | 3 | - |
| 4 | MM-4 | 28 | 12 | 3 | 4 |
| Sample Code | Membrane Thickness (mm) | % Water Retention Capacity | % Moisture Content | % Degradation | % Solution Absorption | |||
|---|---|---|---|---|---|---|---|---|
| 10 min | 20 min | 30 min | 40 min | |||||
| MM-1 | 1.7 | 361 | 79 | 87 | 118 | 128 | 137 | 137 |
| MM-2 | 1.75 | 440 | 91 | 81 | 125 | 136 | 142 | 142 |
| MM-3 | 1.39 | 250 | 86 | 79 | 100 | 112 | 120 | 120 |
| MM-4 | 1.51 | 200 | 70 | 74 | 113 | 125 | 133 | 133 |
Disclaimer/Publisher’s Note: The statements, opinions and data contained in all publications are solely those of the individual author(s) and contributor(s) and not of MDPI and/or the editor(s). MDPI and/or the editor(s) disclaim responsibility for any injury to people or property resulting from any ideas, methods, instructions or products referred to in the content. |
© 2025 by the authors. Licensee MDPI, Basel, Switzerland. This article is an open access article distributed under the terms and conditions of the Creative Commons Attribution (CC BY) license (https://creativecommons.org/licenses/by/4.0/).
Share and Cite
Mujahid, M.; Zubair, M.; Yaqoob, A.; Shahzad, S.; Ullah, A. Formulation and Evaluation of Licorice-Extract-Enhanced Chitosan, PVA, and Gelatin-Derived Hydrogels for Wound Dressing. Bioengineering 2025, 12, 439. https://doi.org/10.3390/bioengineering12050439
Mujahid M, Zubair M, Yaqoob A, Shahzad S, Ullah A. Formulation and Evaluation of Licorice-Extract-Enhanced Chitosan, PVA, and Gelatin-Derived Hydrogels for Wound Dressing. Bioengineering. 2025; 12(5):439. https://doi.org/10.3390/bioengineering12050439
Chicago/Turabian StyleMujahid, Maria, Muhammad Zubair, Asma Yaqoob, Sohail Shahzad, and Aman Ullah. 2025. "Formulation and Evaluation of Licorice-Extract-Enhanced Chitosan, PVA, and Gelatin-Derived Hydrogels for Wound Dressing" Bioengineering 12, no. 5: 439. https://doi.org/10.3390/bioengineering12050439
APA StyleMujahid, M., Zubair, M., Yaqoob, A., Shahzad, S., & Ullah, A. (2025). Formulation and Evaluation of Licorice-Extract-Enhanced Chitosan, PVA, and Gelatin-Derived Hydrogels for Wound Dressing. Bioengineering, 12(5), 439. https://doi.org/10.3390/bioengineering12050439

